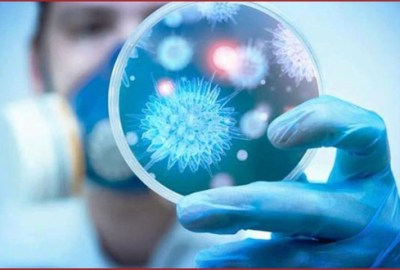

يوميًا في بريطانيا.. 10 مقالات مفبركة عن فيروس كورونا
محمد الحلواني
قالت صحيفة الجارديان إن وحدة الأخبار المفبركة التابعة للحكومة البريطانية، ترصد يوميا حوالي 10 من المقالات والمعلومات المفبركة عن فيروس كورونا المستجد “كوفيد-19”
وأضافت الصحيفة: “اتضح أن بعض المقالات المفبركة تحصل على مشاهدات أكثر من المقالات الموثوقة التي نشرتها خدمة الصحة العامة مجتمعة”.
ونقلت الجارديان عن أوليفر دودن، وزير الثقافة والمسؤول الأول عن الوسائط الرقمية في البلاد، إن وحدة الاستجابة السريعة الجديدة التي شكلتها الحكومة تعكف على رصد وكشف وتكذيب “الشائعات” حول مرض كوفيد-19 الذي يمكن أن يكلف بريطانيا خسائر فادحة في الأرواح.
أحد المقالات المفبركة التي رصدتها الوحدة، هو مقال نشره موقع WND.com ويزعم أن طبيبًا أمريكيًا عالج مئات من مرضى فيروس كورونا وعلى الرغم من أن المعلومات الواردة في المقالة تتعارض مع التوجيهات الرسمية، فقد حظي بأكثر من 160.000 مشاركة على Facebook من قبل المستخدمين في المملكة المتحدة في غضون 24 ساعة.
نرشح لك: السيسي يوجه زيادة بدل المهن الطبية إلى 75%
وكانت مقالة الطبيب، الذي ادعى علاج الأشخاص بعقار مضاد للملاريا والزنك، واحدة من أفضل خمس مقالات تمت مشاركتها حول كوفيد-19 في المملكة المتحدة الأسبوع الماضي.
وصرح دودن للجارديان قائلاً: “نحن بحاجة إلى اتباع نصائح طبية متخصصة والبقاء في المنزل، وحماية خدمة الصحة العامة الوطنية وإنقاذ الأرواح، وتكذب المعلومات المضللة بسرعة. نحن نعمل مع شركات وسائل التواصل الاجتماعي، وسأضغط عليها هذا الأسبوع لاتخاذ مزيد من الإجراءات لوقف انتشار الأكاذيب والشائعات التي يمكن أن تكلف المتابعين أرواحهم”.
وتتكون وحدة الرصد من خبراء في جميع أجهزة الحكومة وقطاع التكنولوجيا. ومن المتوقع أن يتواصل “دودن” بشركات التواصل الاجتماعي مرة أخرى هذا الأسبوع لمناقشة التدابير الأخرى التي يمكن وضعها لضمان وصول معلومات دقيقة وصادقة باستمرار إلى مستخدمي منصاتهم.
وقالت الوزيرة بيني موردانت، المسؤول العام عن الرواتب،: “إن حبس أنفاسك لمدة 10 ثوانٍ ليس اختبارًا لفيروس كورونا، وماء الغرغرة لمدة 15 ثانية ليس علاجًا – هذا هو نوع النصيحة الكاذبة التي رأيناها قادمة من مصادر تدعي أن لديهات خبرة طبية”.
ولهذا السبب، يعمل موظفو الاتصال الحكوميون جنبًا إلى جنب مع الهيئات الصحية لتعزيز المشورة الطبية الرسمية. ولكن يمكن للجمهور أيضًا المساعدة في هذا الجهد، لذلك، ناشدت موردانت باتخاذ بعض الخطوات البسيطة قبل مشاركة المعلومات عبر الإنترنت، مثل قراءة المقال كاملا وعدم الاكتفاء بالعنوان إلى جانب التدقيق في مصدر المعلومات.
نرشح لك: اتهامات بالبخل واستغلال مرضه.. تفاصيل هجوم سيدة على شريف مدكور